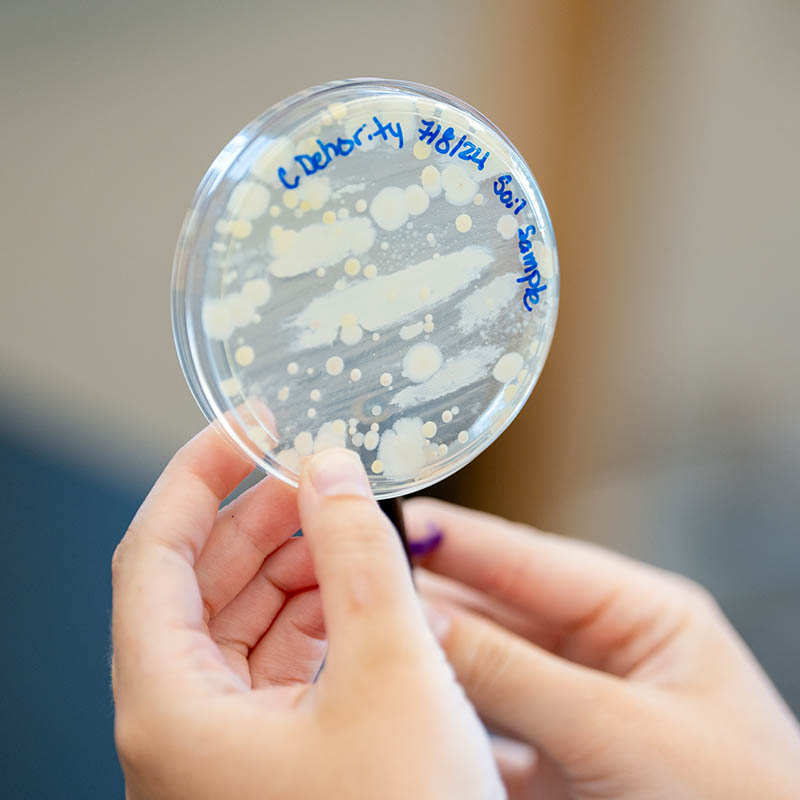

Classroom learning provides a solid foundation of knowledge and theory, but hands-on experience and research projects are crucial in developing critical thinking, problem-solving, and creative skills. Additionally, participating in research projects can provide you with a deeper understanding of the subject, explore career paths, and help you stand out to graduate programs and potential employers. Explore the research programs and student presentation opportunities. If you are a current student, you can also enroll in pre-graduate advising through Canva!
Research Programs

Summer Undergraduate Research Fellowships in the Sciences (SURFS)
The College of Sciences & Mathematics at Belmont University provides a unique and unparalleled summer experience for students of all levels. Our intensive 6-week research project program offers hands-on experience working with a dedicated research team, state-of-the-art equipment and facilities and expert faculty mentors.
Not only will participants receive first-hand exposure to the rigors and rewards of research, they will also have the opportunity to connect with other researchers and expand their knowledge. To support their summer experience, eligible students can apply for a stipend and housing.
Embark on a journey of discovery and growth with the College of Sciences & Mathematics Summer Research Program.
Summer Scholar Communities
The Summer Scholar Communities Program is a unique and immersive experience that combines the best of both worlds - structured coursework and hands-on research. Students will spend 8 - 10 weeks working on a faculty-led research project, dedicating 16 - 18 hours each week to their work alongside a team of peers and expert faculty mentors.
This program distinguishes itself from traditional undergraduate research programs by providing opportunities for interdisciplinary collaboration and exchange through regular joint meetings. In these meetings, students and faculty from diverse fields can come together to share their research findings, learn from each other and expand their perspectives.
Join the Summer Scholar Communities Program for an unforgettable summer of discovery and growth.

The Belmont SPARK Symposium
Our students create incredible scholarships and work campus-wide, and we are excited to showcase the breadth of academic representation across Belmont. From Research to Performance, the Belmont SPARK Symposium is an all-day event dedicated to student Scholarship, Performance, Art, Research and Knowledge!

Science Undergraduate Research Symposium (SURS)
The Science University Research Symposium provides Belmont students an opportunity to present the findings of their independent research projects and enjoy the company of fellow researchers.

Regional and National Professional Conferences
Faculty within the College of Sciences & Mathematics are passionate about providing students with opportunities to present their research findings at national and regional professional conferences. These experiences enhance our students’ communication and presentation skills which are foundational to finding success in the sciences. In a typical year, over one hundred students from the College of Sciences & Mathematics will travel with a faculty member to a regional or national professional college within their discipline, seizing the opportunity to learn about new research findings, network with professionals in the field, and participate in graduate school and job fairs.
Undergraduate Research Seminars & Presentations
BAW is the global campaign to increase public awareness of the progress and benefits of brain research. Every March, the campaign unites efforts of partner organizations worldwide in a celebration of the brain for people of all ages. Belmont Science Departments have hosted on-campus BAW events for the past decade. Recently, CSM students and faculty have included outreach programs in the planned BAW week.
Faculty and students from across the campus attend and listen to faculty present findings in different areas of research. The aims of this seminar series is to promote interdisciplinary research, foster community and create research opportunities for faculty and students across Belmont.
Each semester, departmental representatives invite scientists from their area of expertise to address current topics, expound upon lecture content and expose students to the wide variety of scientific interests.
In the Fall semester of 2016, the College of Sciences & Mathematics began a student/faculty discussion seminar on Faith and Science. This seminar series continues to investigate the interesting and important interface between science and the Christian faith, and better equips students and faculty to discuss these topics with others at Belmont and the broader community. (link to science & religion club page)
The Vaughn Science Lecture is sponsored annually by Dr. Tony Vaughn, a Belmont alumnus and dentist in Franklin, TN. CSM students, faculty and special guests have the opportunity to attend fascinating lectures presented by scientists who are experts in their fields.
Women in Science is a student organization committed to emphasizing the importance of women in STEM fields, making science more relatable and accessible to female students and heightening publicity of Belmont’s science programs.
Contact Us
College of Sciences & Mathematics
1900 Belmont Boulevard
Nashville, TN 37212
Phone: (615) 460-6417